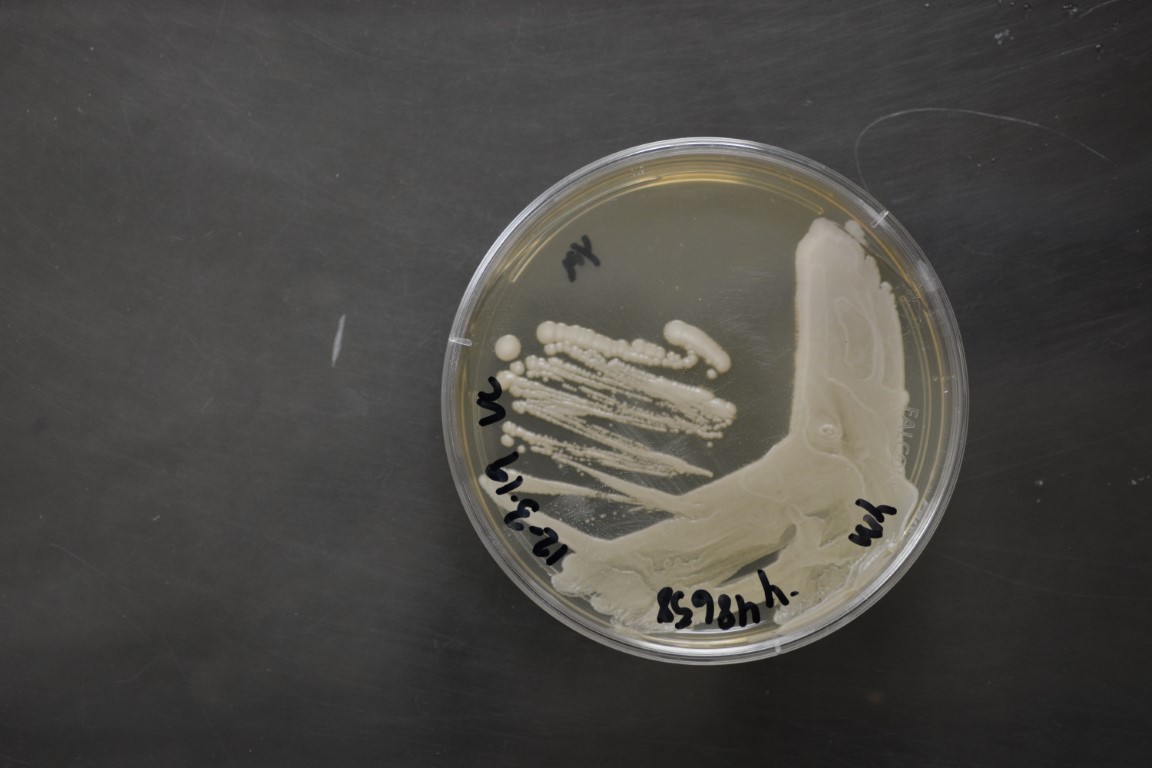

Spathaspora arborariae
NRRL Y-48658(Type Strain)
Accession numbers in other collections:CBS 11463=UFMG-HM19.1A
Source:Carlos A.Rosa,Department of Microbiology,ICB,University Federal de Minas Gerais,Brazil
Isolated from(substrate):TR,rotting wood
Substrate location:Brazil
Genetic info:GenBank:D1/D2(GQ149081).
Growth media:Yeast Extract-Malt Extract-Peptone-Glucose(YM for yeasts)(number 6)
Optimum growth temperature:25C
Strain images:
NRRL_Y-48658_6.JPG